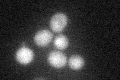
YOR057W
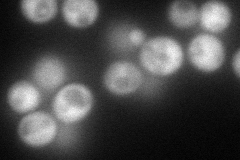
YOR057W
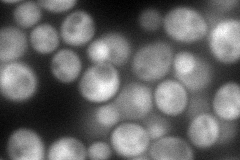
YOR057W
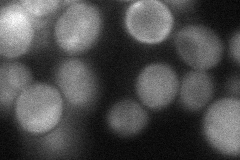
YOR057W
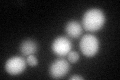
YOR057W
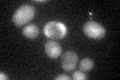
YOR057W

View description
Cochaperone protein; regulates activity of adenylyl cyclase Cyr1p; involved in kinetochore complex assembly; associates with the SCF (Skp1p/Cdc53p/F box protein) ubiquitin ligase complex; acts as a linker between Skp1p and HSP90 complexes
Localization:
Intensity:
Fold change:
Significance:
-
C’ GFP library in SD
cytosol30.34 -
N' NOP1pr-GFP in SD
cytosol122.2 -
N' TEF2pr-mCherry in SD
cytosol150.134 -
N' NATIVEpr-GFP in SD

cytosol22.0005 -
N' TEF2pr-VC and Cyto-VN in SD
cytosol52.2989 -
C’ GFP library in SD+DTT
cytosol41.081.35Yes -
C’ GFP library in SD+H2O2

cytosol38.151.25No -
C’ GFP library in Starvation Media
cytosol60.641.99Yes -
C’ GFP library on the background of Pup2-DaMP

cytosol -
C’ GFP library on the background of CCT mutant

cytosol42.64861.40546Yes
